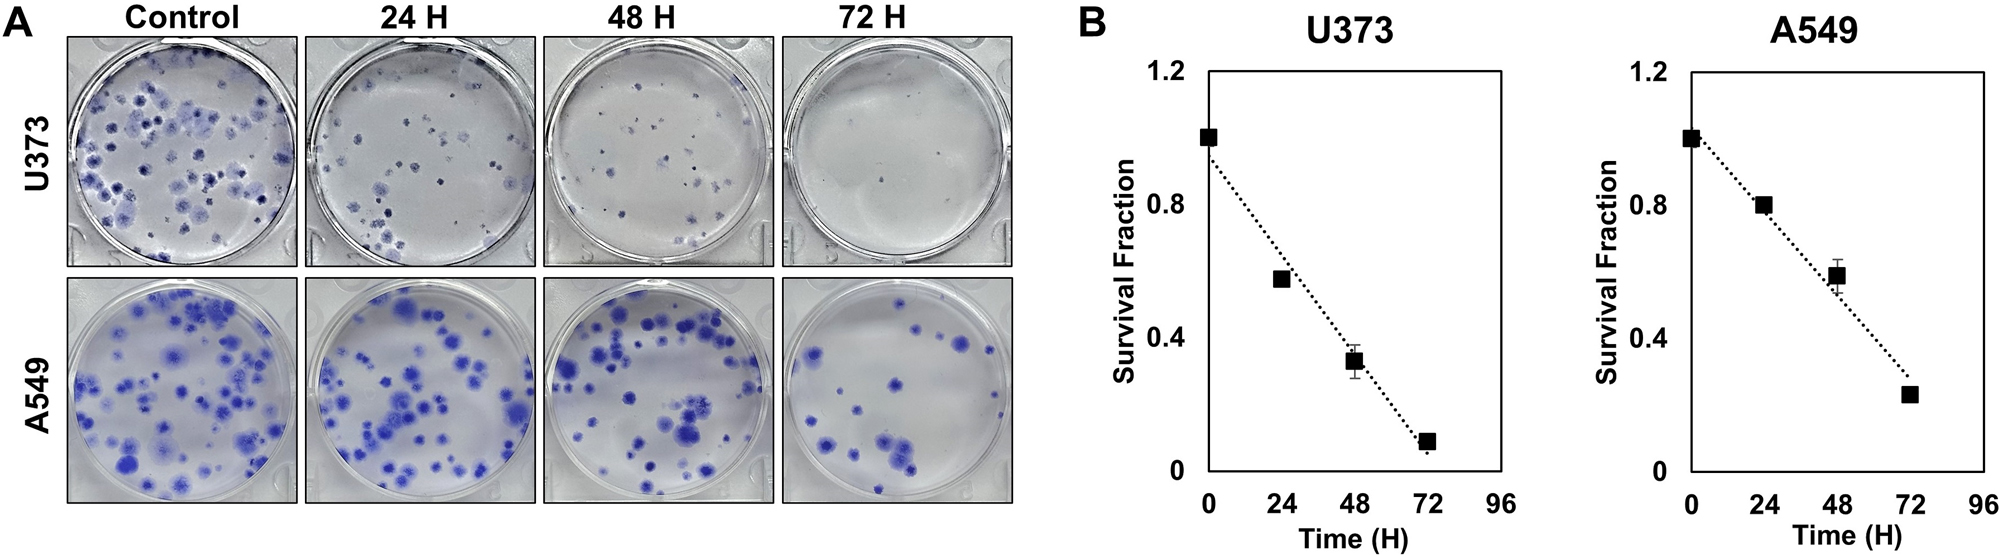

Abstract
Objectives
Hyperthermia enhances tumor sensitivity to treatments like radiotherapy and chemotherapy, but high temperatures (42–45 °C) can damage normal tissues, especially heat-sensitive neuronal cells. This study aims to examine the effects of mild hyperthermia (39–41 °C) on glioblastoma (GBM) and non-small cell lung cancer (NSCLC) cell lines to determine its therapeutic potential while minimizing normal tissue damage.
Methods
GBM (U373, A172) and NSCLC (A549, H460) cells were exposed to mild hyperthermia for up to 72 h. Cell viability was assessed using the MTT assay, while apoptosis was analyzed via annexin V staining and cleaved-PARP expression through flow cytometry and Western blotting. Clonogenic survival was evaluated to determine long-term effects.
Results
Cell viability decreased in a temperature- and time-dependent manner, with A549 cells exhibiting a ∼40 % reduction after 72 h at 40 °C. Apoptosis markers, annexin V and cleaved-PARP, showed time-dependent increases, confirming apoptotic induction (p<0.01). Clonogenic assays demonstrated significantly lower survival fractions following prolonged exposure, indicating reduced tumorigenic potential.
Conclusions
Mild hyperthermia effectively reduces cancer cell viability and induces apoptosis in GBM and NSCLC cells while minimizing potential damage to normal tissues. These findings suggest that optimizing temperature and exposure time can enhance hyperthermia’s therapeutic efficacy, making it a promising strategy for safer and more effective cancer treatment.
Introduction
Hyperthermia is a well-established adjuvant cancer therapy, frequently used in combination with surgery, radiotherapy, chemotherapy, and immunotherapy [1], [2], [3], [4], [5]. It is employed in thermal ablation, where localized heating selectively destroys tumor tissues [6], controlled drug delivery, where heat-sensitive carriers enable targeted chemotherapy release [7], 8], and thermo-radiotherapy, which enhances the effects of radiotherapy by increasing tumor oxygenation and radiosensitivity [9], [10], [11].
By elevating tissue temperature through external heat sources, hyperthermia can destroy cancer cells and/or inhibit their proliferation [12]. Its application varies depending on tumor type and location, including local, regional, and systemic hyperthermia [13], 14]. Its therapeutic effects include enhanced tumor oxygenation, increased sensitivity to other treatments, and, at higher temperatures, direct induction of cell death [15], [16], [17]. Physiologically, hyperthermia improves vascular permeability and alters tumor metabolism, reducing hypoxia and boosting radiosensitivity [18]. On a molecular level, hyperthermia inhibits multiple DNA repair pathways, including base excision repair (BER), nucleotide excision repair (NER), non-homologous end joining (NHEJ), and homologous recombination (HR), by disrupting critical proteins and interfering with cell cycle checkpoints [19], [20], [21]. This dual impact on the tumor microenvironment and DNA repair mechanisms enhances the efficacy of radiotherapy and chemotherapy.
Despite its established use, a key research gap remains in optimizing hyperthermia conditions to balance efficacy and safety. Preclinical studies have demonstrated that hyperthermia is effective within specific temperature ranges and times of treatment. Typically, therapeutic hyperthermia is applied at temperatures ranging from 40 °C to 45 °C [22], 23], with the optimal temperature range for achieving significant antitumor effects generally considered to be between 42 °C and 45 °C [1], 24]. For example, studies on perfusion hyperthermia without adjunctive cytotoxic drugs have shown that maintaining a temperature of approximately 43 °C for 2 h can yield effective results [25]. Most normal tissues can tolerate temperatures up to 44 °C for 1 h without sustaining significant damage [26]. Neural tissues, however, have been shown to be more sensitive, with temperatures above 42 °C for 1 h resulting in irreversible damage to normal tissues in animal models [27]. Reducing the temperature to below 43 °C and extending the time of exposure may minimize the side effects of hyperthermia while maintaining its therapeutic efficacy. This approach may be safer than conventional hyperthermia protocols, as it can reduce the thermal burden on healthy cells and tissues, particularly those more sensitive to heat, such as neural tissues. Optimizing temperature and duration of exposure with therapeutic outcomes may enhance the safety profile of hyperthermia treatments in oncology.
Although most research on hyperthermia has focused on higher temperatures due to their efficiency relative to treatment duration, mild hyperthermia at temperatures below 43 °C, when applied over prolonged periods, has also been shown to achieve effective tumor control [28], 29]. These findings suggest that prolonged hyperthermia at lower temperatures may induce a time-dependent reduction in cell survival rates, indicating its potential as an effective treatment strategy.
The present study aims to investigate the effects of hyperthermia, applied at temperatures of 39–41 °C for various periods of time, on cancer cells, thereby determining whether these lower temperatures yield effective therapeutic outcomes while minimizing the side effects associated with higher temperatures. Human glioblastoma (GBM) and non-small cell lung cancer (NSCLC) cell lines were selected as models, given the growing interest in hyperthermia as a promising adjuvant treatment for both cancer types.
Materials and methods
Cancer cell cultures
Human glioblastoma (GBM) (U373, A172) and non-small cell lung cancer (NSCLC) (A549, H460) cell lines were obtained from the Korean Cell Line Bank (Seoul, South Korea) after passing authentication and mycoplasma testing. U373 and A172 cells were cultured in Dulbecco’s Modified Eagle’s Medium (DMEM) supplemented with 10 % fetal bovine serum (FBS), glutamine, 4-(2-hydroxyethyl)-1-piperazineethanesulfonic acid (HEPES), and antibiotics at 37 °C in a 5 % CO2 humidified incubator. A549 and H460 cells were cultured in Roswell Park Memorial Institute 1,640 medium (RPMI 1640) supplemented with 10 % FBS, glutamine, HEPES, and antibiotics at 37 °C in a 5 % CO2 humidified incubator.
Antibodies and chemicals
Anti-cleaved poly (ADP-ribose) polymerase (PARP) (#9541) and anti-beta actin (#3700) antibodies were obtained from Cell Signaling Technology (Danvers, MA, USA).
Experimental setup
Cancer cells were uniformly seeded (5×104 cells/dish) into dishes and incubated at 38 °C for 24 h. The dishes were then transferred to an incubator set at the designated experimental temperature (39–41 °C) and further incubated for 24–72 h. The temperature of the control group was consistently maintained at 38 °C until the end of the experiment. To ensure that the culture medium accurately reached the intended temperature, the temperature of a dummy dish containing only medium was measured. To minimize external temperature fluctuations, all culture dishes were isolated within the incubator, preventing exposure to ambient air. The temperature of the culture medium was continuously monitored using a thermometer to maintain stability throughout the experiment. At the end of the experiment, cell morphology was observed and photographed under a light microscope (TS100, Nikon Corporation, Japan) at 40×magnification.
MTT assay
Cells were seeded at a density of 2000 cells/well in a 96-well plate and incubated for 24 h, in accordance with the indicated experimental conditions. To quantify cell viability, an equal volume of culture medium containing EZ-Cytox reagent (EZ3000, Daeillab Service, Chungcheongbuk-do, South Korea) was added to the cells, and the mixture was incubated for 2 h. Cell viability was determined by measuring the absorbance at 450 nm using a microplate reader (PHOmo, Autobio Diagnostics Co., Ltd, Zhengzhou, China).
Flow cytometry
U373 and A549 cells were cultured, harvested at the indicated times, and stained with propidium iodide (PI) and annexin V according to the manufacturer’s instructions (K101-400, Biovision, CA, USA). The cells were analyzed using an Accuri C6 Plus flow cytometer (BD Biosciences, San Jose, CA, United States). Each sample consisted of a minimum of 10,000 cells.
Western blotting
Following treatment, U373 and A549 cells were lysed using RIPA buffer to extract total proteins. A total of 30 μg of protein per sample was loaded and separated by SDS-PAGE. Sample Loading Buffer was also loaded into a separate well as a reference (#84788, Thermo Fisher Scientific Inc., MA, USA). The separated proteins were then transferred onto nitrocellulose membranes. After the transfer, the membranes were blocked overnight at 4 °C with 1 % (v/v) nonfat dried milk dissolved in Tris-buffered saline containing 0.05 % Tween 20 (TBST) to prevent nonspecific binding. The membranes were then incubated with the appropriate primary antibodies, diluted at 1:1,000, followed by washing with TBST. Subsequently, the membranes were incubated with HRP-conjugated secondary antibodies diluted at 1:5,000 for 1 h at room temperature. β-Actin was used as an internal loading control to ensure equal protein loading across samples. Immunoreactive protein bands were finally detected and visualized using the iBright imaging system (Invitrogen, Thermo Fisher Scientific Inc., MA, USA). All experiments were independently repeated three times to ensure reproducibility.
Clonogenic assay
U373 and A549 cells were seeded at approximately 200 cells per well in 6-well plates and incubated for 24 h to allow stabilization. The cells were subsequently exposed to heat at the designated temperature and incubated in a CO2 incubator to allow colony formation. After 15–20 days, colonies were stained with 0.4 % crystal violet (Sigma, St. Louis, MO, USA). The plating efficiency indicates the percentage of seeded cells of a particular cell line that formed colonies under specific culture conditions. The survival fraction, expressed as a function of irradiation, was calculated as follows:
Statistical analysis
Means were compared using Student’s t-tests, with differences considered statistically significant at a p-value of <0.05 or<0.01. A threshold of p<0.05 was used to identify statistically significant differences, while a more stringent criterion of p<0.01 was applied to highlight highly significant effects, reducing the likelihood of false positives in key comparisons. This dual significance approach ensures both sensitivity in detecting meaningful trends and rigor in confirming robust differences. All statistical analyses were performed using Microsoft Excel (Office 2016, Microsoft, Redmond, WA, USA), and data are presented as mean ± standard deviation (SD). Statistical significance is indicated as *p<0.05 and **p<0.01.
Results
The sensitivity of the GBM cell lines U373 and A172 and the NSCLC cell lines H460 and A549 to mild hyperthermia (39–41 °C) was tested by measuring cell viability after incubation at various temperatures for 72 h. All four cell lines showed temperature-dependent reductions in viability, even at 39 °C and 40 °C (Figure 1). The four cell lines varied in their sensitivity to higher temperatures, with viability at 41 °C for 72 h measured at approximately 52 % for U373, 69 % for A172, 45 % for A549, and 32 % for H460, relative to the control group, indicating that A172 exhibits the greatest resistance to thermal stress.

Viability of the glioblastoma cell lines U373 and A172 and the non-small cell lung cancer (NSCLC) cell lines A549 and H460 after 72 h of exposure to hyperthermia at 39–41 °C compared with control cells, as measured by MTT assays. The values represent the means ± SDs of three independent experiments. *p<0.05, **p<0.01.
The effects of duration of mild hyperthermia on cell viability were also investigated in these GBM and NSCLC cell lines. The cells were incubated at 40 °C, a temperature lower than the previously established effective treatment temperature of 43 °C, for 24, 48, and 72 h. Although the sensitivity of these cell lines differed, all exhibited a reduction in cell viability with increased exposure time (Figure 2). Specifically, compared with control cells, the A549 NSCLC cell line showed an approximately 40 % reduction in viability after 72 h at 40 °C, suggesting that prolonged mild hyperthermia may effectively inhibit cancer cell proliferation.

Effects of duration of mild hyperthermia at 40 °C on the viability of glioblastoma and non-small cell lung cancer (NSCLC) cell lines A549 and H460. Cells were exposed to hyperthermia at 40 °C for 24–72 h (A) Microscopic images were taken, and (B) cell viability, compared with control cells, was measured by MTT assays. Scale bar=500 μm. The values represent the means ± SDs of three independent experiments. *p<0.05, **p<0.01.
Four cell lines were initially employed to assess overall response trends to mild hyperthermia. Subsequently, a representative GBM and NSCLC cell line was chosen to conduct more detailed mechanistic studies. Based on these findings, one representative GBM (U373) and one NSCLC (A549) cell line were selected for more detailed investigations.
Because hyperthermia has been reported to induce apoptosis in various types of cancer cells [30], [31], [32], the present study assessed whether mild hyperthermia at 40 °C could induce apoptosis in GBM and NSCLC cell lines. U373 and A549 cells were incubated at 40 °C for 24, 48, and 72 h, and the levels of expression of the apoptosis markers, annexin V and cleaved-poly (ADP-ribose) polymerase (PARP), were quantified. Flow cytometry showed time-dependent increases in annexin V-positive GBM and NSCLC cells, and Western blotting showed time-dependent increases in cleaved-PARP levels in these cells, suggesting that apoptosis is induced by mild hyperthermia (Figure 3).

Effects of duration of mild hyperthermia at 40 °C on apoptosis markers in glioblastoma and non-small cell lung cancer (NSCLC) cell lines. Cells were exposed to hyperthermia at 40 °C for 24–72 h. Levels of expression of cleaved-PARP were analyzed by (A) Western blotting, and (B) numbers of annexin V-positive cells were measured by flow cytometry. The values represent the means ± SDs of three independent experiments. *p<0.05.
Furthermore, the surviving fractions of these GBM and NSCLC cells subjected to mild hyperthermia at 40 °C over time were determined using a clonogenic assay (Figure 4A). The surviving fractions of both cell lines decreased progressively over time (Figure 4B), further suggesting that mild hyperthermia is an effective therapeutic strategy.
The results of clonogenic assays (A) Photographs and (B) survival curves from clonogenic assays of glioblastoma and non-small cell lung cancer (NSCLC) cell lines exposed to hyperthermia at 40 °C for 24–72 h.
Discussion
Hyperthermia has shown both advantages and disadvantages in cancer treatment [27]. It enhances radiotherapy and chemotherapy efficacy by increasing tumor oxygenation, disrupting DNA repair, and promoting apoptosis [13], 33]. Additionally, it stimulates immune responses via heat shock proteins (HSPs) and improves drug delivery by increasing blood flow, facilitating deeper penetration of chemotherapeutic agents [34], 35].
To maximize these benefits, hyperthermia can be applied through localized, regional, or whole-body methods [13]. It is commonly combined with radiotherapy and chemotherapy to improve effectiveness while minimizing normal tissue damage. Nanoparticle-mediated hyperthermia offers precise thermal control and tumor-specific heating, reducing off-target effects [35]. Clinically, it has shown improved survival rates in soft tissue sarcomas, cervical cancer, and recurrent breast cancer [36], [37], [38].
However, hyperthermia also presents risks, particularly to heat-sensitive tissues [39]. Neural tissues are especially vulnerable, with risks including neuronal apoptosis, inflammation, nerve damage, burns, and cognitive impairment [40], [41], [42], [43]. These challenges underscore the need for precise temperature monitoring and individualized treatment planning to ensure safety and efficacy.
Given these concerns, optimizing the therapeutic window of hyperthermia is essential to maximize its oncological benefits while minimizing damage to surrounding healthy tissues [44]. Managing this balance requires a deep understanding of thermal dosimetry and the physiological responses of different tissue types. Even slight temperature elevations have been linked to significant adverse outcomes in the central nervous system (CNS), with potential long-term neurological sequelae [45]. Case reports describe patients experiencing neurological deficits, including permanent motor dysfunction and sensory loss, reinforcing the importance of careful thermal dosimetry to mitigate these risks. This is particularly concerning, as neuronal damage may result not only in acute symptoms but in chronic cognitive deficits, further complicating patient recovery and quality of life [40].
The results of the present study suggest that mild hyperthermia, ranging from 39-41 °C, may be a viable alternative to standard hyperthermia at 42–45 °C. The application of mild hyperthermia for an extended period of time may achieve therapeutic effects similar to those of higher temperatures for a shorter time, while significantly reducing the risk of damage to normal tissues. This method is based on the sensitivity of cancer cells to even modest increases in temperature, thereby maintaining efficacy while minimizing collateral damage to surrounding healthy tissues.
The results of this study demonstrate that prolonged exposure at reduced temperatures can have significant anti-tumor activity. These findings suggest that treatment duration, rather than temperature alone, plays a crucial role in determining the efficacy of hyperthermia as a cancer treatment modality. Additionally, mild hyperthermia was found to effectively induce apoptosis of these cell lines, as evidenced by the expression of markers annexin V and cleaved-PARP, suggesting that mild hyperthermia not only slows tumor growth but participates in the destruction of cancer cells.
While our study confirms apoptosis induction following mild hyperthermia, the precise underlying mechanisms remain to be fully elucidated. The observed increase in cleaved-PARP expression suggests that DNA damage plays a role in this process. However, further investigations, including analyses of other apoptosis-related pathways and potential upstream regulators, are needed to provide a more comprehensive understanding of hyperthermia-induced cell death.
In addition, an important limitation of this study is that all experiments were conducted in vitro. The lack of in vivo validation leaves uncertainties regarding the tumor microenvironment’s influence on hyperthermia treatment. Future studies should incorporate animal models to evaluate the systemic effects of mild hyperthermia and its interactions with the immune system and surrounding tissues.
Previous studies have reported that neural cells, which are highly sensitive to heat, exhibit toxicity after approximately 1 h of heating in hyperthermia [46], 47]. This study proposed mild hyperthermia as a potential alternative to mitigate this adverse effect. While mild hyperthermia offers advantages in short-term treatments, data on its effects over prolonged durations (24–72 h) remain limited. Therefore, further research is needed to support and expand the findings of this study.
The implications of this study are significant, suggesting that future clinical protocols should include exposure of tumors to lower temperatures for a longer period of time. These protocols may enhance patient safety without compromising the therapeutic efficacy of hyperthermia. Further investigation into the molecular mechanisms underlying the differential responses of various cancer cell types to mild hyperthermia could lead to more personalized and targeted treatment strategies.
Finally, studies should investigate the effects of combinations of mild hyperthermia with other treatment modalities, such as chemotherapy and immunotherapy. Previous clinical trials have demonstrated that hyperthermia, when combined with brachytherapy, significantly improves survival in glioblastoma patients by enhancing the therapeutic efficacy of radiation therapy [48]. These findings suggest that incorporating mild hyperthermia into multimodal treatment strategies may further optimize treatment outcomes. Future research should explore the potential synergistic effects of mild hyperthermia with chemotherapy and immunotherapy, which could improve tumor control while minimizing toxicity.
Conclusions
In conclusion, the present study showed that mild hyperthermia at 39–41 °C, applied over extended periods of time, can effectively reduce the viability of GBM and NSCLC cell lines while minimizing damage to normal tissues. These findings suggest that balancing temperature and treatment duration is key to optimizing the efficacy and safety of hyperthermia, making it a promising alternative in cancer therapy. Further research should explore whether combinations of mild hyperthermia with other treatment modalities, such as chemotherapy and immunotherapy, result in enhanced therapeutic outcomes.
Acknowledgments
We gratefully acknowledge the support provided by the National Research Foundation of Korea (NRF) funded by the Korean government (MSIT) (Grant Nos. 2021R1A2C2008695 and 2022R1A2C1010337). We also extend our appreciation to the Korea Medical Device Development Fund, funded by the Korean Government (the Ministry of Science and ICT, the Ministry of Trade, Industry and Energy, the Ministry of Health & Welfare, and the Ministry of Food and Drug Safety) (Project No. RS-2023-00254868), for their generous support.
-
Research ethics: Not applicable.
-
Informed consent: Not applicable.
-
Author contributions: Yunhui Jo designed and conducted the experiments, collected the data, and wrote the manuscript. Jinju Heo contributed to the experiments and data collection. Myonggeun Yoon conceived the study and supervised the overall project. All authors have accepted responsibility for the entire content of this manuscript and approved its submission.
-
Use of Large Language Models, AI and Machine Learning Tools: None declared.
-
Conflict of interest: The authors report no conflict of interest.
-
Research funding: This work was supported by grants from the National Research Foundation of Korea (NRF) funded by the Korean government (MSIT) (Grant Nos. 2021R1A2C2008695 and 2022R1A2C1010337), and also supported by the Korea Medical Device Development Fund, funded by the Korean Government (Ministry of Science and ICT, Ministry of Trade, Industry and Energy, Ministry of Health & Welfare, and Ministry of Food and Drug Safety) (Project No. RS-2023-00254868).
-
Data availability: The raw data can be obtained on request from the corresponding author.
References
1. Behrouzkia, Z, Joveini, Z, Keshavarzi, B, Eyvazzadeh, N, Aghdam, RZ. Hyperthermia: how can it be used? Oman Med J 2016;31:89–97. https://doi.org/10.5001/omj.2016.19.Search in Google Scholar PubMed PubMed Central
2. Crezee, J, Franken, NA, Oei, AL. Hyperthermia-based anti-cancer treatments. Cancers (Basel) 2021;13:1240. https://doi.org/10.3390/cancers13061240.Search in Google Scholar PubMed PubMed Central
3. Li, Y, Wang, D, Ping, X, Zhang, Y, Zhang, T, Wang, L, et al.. Local hyperthermia therapy induces browning of white fat and treats obesity. Cell 2022;185:949–66. e19. https://doi.org/10.1016/j.cell.2022.02.004.Search in Google Scholar PubMed
4. Mirzaghavami, PS, Khoei, S, Khoee, S, Shirvalilou, S, Mahdavi, SR, Mahabadi, VP. Radio-sensitivity enhancement in HT29 cells through magnetic hyperthermia in combination with targeted nano-carrier of 5-Flourouracil. Mater Sci Eng C 2021;124:112043. https://doi.org/10.1016/j.msec.2021.112043.Search in Google Scholar PubMed
5. Righini, MF, Durham, A, Tsoutsou, PG. Hyperthermia and radiotherapy: physiological basis for a synergistic effect. Front Oncol 2024;14:1428065. https://doi.org/10.3389/fonc.2024.1428065.Search in Google Scholar PubMed PubMed Central
6. Lopresto, V, Pinto, R, Farina, L, Cavagnaro, M. Microwave thermal ablation: effects of tissue properties variations on predictive models for treatment planning. Med Eng Phys 2017;46:63–70. https://doi.org/10.1016/j.medengphy.2017.06.008.Search in Google Scholar PubMed
7. Adabbo, G, Andreozzi, A, Iasiello, M, Vanoli, G. Numerical evaluation of heat-triggered drug release via thermo-sensitive liposomes: a comparison between image-based vascularized tumor and volume-averaged porous media models. Int J Heat Mass Transfer 2024;220:124942. https://doi.org/10.1016/j.ijheatmasstransfer.2023.124942.Search in Google Scholar
8. Ni, LP, Sun, HT, Wang, P, Wang, J, Zhou, JH, Cao, RQ, et al.. Hyperthermia enhances the efficacy of chemotherapeutic drugs in heat-sensitive cells through interfering with DNA damage repair. Ann Transl Med 2022;10:463. https://doi.org/10.21037/atm-22-955.Search in Google Scholar PubMed PubMed Central
9. Kok, H, Van Rhoon, G, Herrera, T, Overgaard, J, Crezee, J. Biological modeling in thermoradiotherapy: present status and ongoing developments toward routine clinical use. Int J Hyperthermia 2022;39:1126–40. https://doi.org/10.1080/02656736.2022.2113826.Search in Google Scholar PubMed
10. Kwon, S, Jung, S, Baek, SH. Combination therapy of radiation and hyperthermia, focusing on the synergistic anti-cancer effects and research trends. Antioxidants 2023;12:924. https://doi.org/10.3390/antiox12040924.Search in Google Scholar PubMed PubMed Central
11. Le Guevelou, J, Chirila, ME, Achard, V, Guillemin, PC, Lorton, O, Uiterwijk, JW, et al.. Combined hyperthermia and radiotherapy for prostate cancer: a systematic review. Int J Hyperther 2022;39:547–56. https://doi.org/10.1080/02656736.2022.2053212.Search in Google Scholar PubMed
12. Hegyi, G, Szigeti, GP, Szász, A. Hyperthermia versus oncothermia: cellular effects in complementary cancer therapy. Evid base Compl Alternative Med 2013;2013:672873. https://doi.org/10.1155/2013/672873.Search in Google Scholar PubMed PubMed Central
13. Datta, N, Ordóñez, SG, Gaipl, U, Paulides, M, Crezee, H, Gellermann, J, et al.. Local hyperthermia combined with radiotherapy and-/or chemotherapy: recent advances and promises for the future. Cancer Treat Rev 2015;41:742–53. https://doi.org/10.1016/j.ctrv.2015.05.009.Search in Google Scholar PubMed
14. Peeters, H, van Zwol, E, Brancato, L, Mc da Cunha, M, Bogers, J. Systematic review of the registered clinical trials for oncological hyperthermia treatment. Int J Hyperther 2022;39:806–12. https://doi.org/10.1080/02656736.2022.2076292.Search in Google Scholar PubMed
15. Shevelev, O, Petrova, M, Smolensky, A, Osmonov, B, Toimatov, S, Kharybina, T, et al.. Using medical microwave radiometry for brain temperature measurements. Drug Discov Today 2022;27:881–9. https://doi.org/10.1016/j.drudis.2021.11.004.Search in Google Scholar PubMed
16. Wust, P, Hildebrandt, B, Sreenivasa, G, Rau, B, Gellermann, J, Riess, H, et al.. Hyperthermia in combined treatment of cancer. Lancet Oncol 2002;3:487–97. https://doi.org/10.1016/s1470-2045(02)00818-5.Search in Google Scholar PubMed
17. Field, S, Bleehen, N. Hyperthermia in the treatment of cancer. Cancer Treat Rev 1979;6:63–94. https://doi.org/10.1016/s0305-7372(79)80043-2.Search in Google Scholar PubMed
18. Vujaskovic, Z, Song, C. Physiological mechanisms underlying heat-induced radiosensitization. Int J Hyperther 2004;20:163–74. https://doi.org/10.1080/02656730310001619514.Search in Google Scholar PubMed
19. Oei, AL, Vriend, LE, Crezee, J, Franken, NA, Krawczyk, PM. Effects of hyperthermia on DNA repair pathways: one treatment to inhibit them all. Radiat Oncol 2015;10:1–13. https://doi.org/10.1186/s13014-015-0462-0.Search in Google Scholar PubMed PubMed Central
20. Wu, Y, Liu, P, Chen, W, Bai, S, Chen, S, Chen, J, et al.. Microwave hyperthermia enhances radiosensitization by decreasing DNA repair efficiency and inducing oxidative stress in PC3 prostatic adenocarcinoma cells. Int J Hyperther 2024;41:2335201. https://doi.org/10.1080/02656736.2024.2335201.Search in Google Scholar PubMed
21. Lukácsi, S, Munkácsy, G, Győrffy, B. Harnessing hyperthermia: molecular, cellular, and immunological insights for enhanced anticancer therapies. Integr Cancer Therapies 2024;23:15347354241242094. https://doi.org/10.1177/15347354241242094.Search in Google Scholar PubMed PubMed Central
22. Bakker, A, van der Zee, J, van Tienhoven, G, Kok, HP, Rasch, CR, Crezee, H. Temperature and thermal dose during radiotherapy and hyperthermia for recurrent breast cancer are related to clinical outcome and thermal toxicity: a systematic review. Int J Hyperther 2019;36:1023–38. https://doi.org/10.1080/02656736.2019.1665718.Search in Google Scholar PubMed
23. Falk, M, Issels, R. Hyperthermia in oncology. Int J Hyperther 2001;17:1–18. https://doi.org/10.1080/02656730118511.Search in Google Scholar
24. Kanaya, Y, Doihara, H, Shiroma, K, Ogasawara, Y, Date, H. Effect of combined therapy with the antiestrogen agent toremifene and local hyperthermia on breast cancer cells implanted in nude mice. Surg Today 2008;38:911–20. https://doi.org/10.1007/s00595-007-3730-2.Search in Google Scholar PubMed
25. Bettaieb, A, Wrzal, PK, Averill-Bates, DA. Hyperthermia: cancer treatment and beyond. Cancer Treat Conv Innovat Approaches 2013:257–83.10.5772/55795Search in Google Scholar
26. Fajardo, LG. Pathological effects of hyperthermia in normal tissues. Cancer Res 1984;44(10_Supplement):4826s–35s.Search in Google Scholar
27. Sminia, P, Zee, JVD, Wondergem, J, Haveman, J. Effect of hyperthermia on the central nervous system: a review. Int J hyperthermia 1994;10:1–30. https://doi.org/10.3109/02656739409009328.Search in Google Scholar PubMed
28. Mackey, MA. In vitro effects and biological potential of long duration, moderate hyperthermia. In: Seegenschmiedt, MH, Sauer, R, editors. Interstitial and intracavitary thermoradiotherapy. Medical radiology. Berlin, Heidelberg: Springer; 1993.10.1007/978-3-642-84801-8_3Search in Google Scholar
29. Armour, EP, McEachern, D, Wang, Z, Corry, PM, Martinez, A. Sensitivity of human cells to mild hyperthermia. Cancer Res 1993;53:2740–4.Search in Google Scholar
30. Hou, CH, Lin, FL, Hou, SM, Liu, JF. Hyperthermia induces apoptosis through endoplasmic reticulum and reactive oxygen species in human osteosarcoma cells. Int J Mol Sci 2014;15:17380–95. https://doi.org/10.3390/ijms151017380.Search in Google Scholar PubMed PubMed Central
31. Ahmed, K, Tabuchi, Y, Kondo, T. Hyperthermia: an effective strategy to induce apoptosis in cancer cells. Apoptosis 2015;20:1411–9. https://doi.org/10.1007/s10495-015-1168-3.Search in Google Scholar PubMed
32. Luo, Z, Zheng, K, Fan, Q, Jiang, X, Xiong, D. Hyperthermia exposure induces apoptosis and inhibits proliferation in HCT116 cells by upregulating miR-34a and causing transcriptional activation of p53. Exp Ther Med 2017;14:5379–86. https://doi.org/10.3892/etm.2017.5257.Search in Google Scholar PubMed PubMed Central
33. Mantel, F, Frey, B, Haslinger, S, Schildkopf, P, Sieber, R, Ott, OJ, et al.. Combination of ionising irradiation and hyperthermia activates programmed apoptotic and necrotic cell death pathways in human colorectal carcinoma cells. Strahlentherapie und Onkologie 2010;186:587–99. https://doi.org/10.1007/s00066-010-2154-x.Search in Google Scholar PubMed
34. Kaur, P, Hurwitz, MD, Krishnan, S, Asea, A. Combined hyperthermia and radiotherapy for the treatment of cancer. Cancers 2011;3:3799–823. https://doi.org/10.3390/cancers3043799.Search in Google Scholar PubMed PubMed Central
35. Zhang, Y, Li, Z, Huang, Y, Zou, B, Xu, Y. Amplifying cancer treatment: advances in tumor immunotherapy and nanoparticle-based hyperthermia. Front Immunol 2023;14:1258786. https://doi.org/10.3389/fimmu.2023.1258786.Search in Google Scholar PubMed PubMed Central
36. Issels, RD, Lindner, LH, Verweij, J, Wessalowski, R, Reichardt, P, Wust, P, et al.. Effect of neoadjuvant chemotherapy plus regional hyperthermia on long-term outcomes among patients with localized high-risk soft tissue sarcoma: the EORTC 62961-ESHO 95 randomized clinical trial. JAMA Oncol 2018;4:483–92. https://doi.org/10.1001/jamaoncol.2017.4996.Search in Google Scholar PubMed PubMed Central
37. Datta, NR, Jain, BM, Mathi, Z, Datta, S, Johari, S, Singh, AR, et al.. Hyperthermia: a potential game-changer in the management of cancers in low-middle-income group countries. Cancers 2022;14:315. https://doi.org/10.3390/cancers14020315.Search in Google Scholar PubMed PubMed Central
38. Maluta, S, Kolff, MW. Role of hyperthermia in breast cancer locoregional recurrence: a review. Breast Care 2015;10:408–12. https://doi.org/10.1159/000440792.Search in Google Scholar PubMed PubMed Central
39. Van der Zee, J. Heating the patient: a promising approach? Ann Oncol 2002;13:1173–84. https://doi.org/10.1093/annonc/mdf280.Search in Google Scholar PubMed
40. Walter, EJ, Carraretto, M. The neurological and cognitive consequences of hyperthermia. Crit Care 2016;20:1–8. https://doi.org/10.1186/s13054-016-1376-4.Search in Google Scholar PubMed PubMed Central
41. Sun, G, Yang, X, Jiang, Q, Liu, K, Li, B, Li, L, et al.. Hyperthermia impairs the executive function using the Attention Network Test. Int J Hyperther 2012;28:621–6. https://doi.org/10.3109/02656736.2012.705217.Search in Google Scholar PubMed
42. Racinais, S, Gaoua, N, Grantham, J. Hyperthermia impairs short-term memory and peripheral motor drive transmission. J Physiol 2008;586:4751–62. https://doi.org/10.1113/jphysiol.2008.157420.Search in Google Scholar PubMed PubMed Central
43. Sun, G, Li, L, Li, M, Jiang, Q. Hyperthermia impaired pre-attentive processing: an auditory MMN study. Neurosci Lett 2011;502:94–8. https://doi.org/10.1016/j.neulet.2011.07.029.Search in Google Scholar PubMed
44. Song, CW. Effect of local hyperthermia on blood flow and microenvironment: a review. Cancer Res 1984;44(10_Supplement):4721s–30s.Search in Google Scholar
45. Critchley, HD, Wiens, S, Rotshtein, P, Öhman, A, Dolan, RJ. Neural systems supporting interoceptive awareness. Nat Neurosci 2004;7:189–95. https://doi.org/10.1038/nn1176.Search in Google Scholar PubMed
46. Dewhirst, MW, Viglianti, B, Lora-Michiels, M, Hanson, M, Hoopes, P. Basic principles of thermal dosimetry and thermal thresholds for tissue damage from hyperthermia. Int J Hyperther 2003;19:267–94. https://doi.org/10.1080/0265673031000119006.Search in Google Scholar PubMed
47. Yarmolenko, PS, Moon, EJ, Landon, C, Manzoor, A, Hochman, DW, Viglianti, BL, et al.. Thresholds for thermal damage to normal tissues: an update. Int J Hyperther 2011;27:320–43. https://doi.org/10.3109/02656736.2010.534527.Search in Google Scholar PubMed PubMed Central
48. Sneed, PK, Stauffer, PR, McDermott, MW, Diederich, CJ, Lamborn, KR, Prados, MD, et al.. Survival benefit of hyperthermia in a prospective randomized trial of brachytherapy boost±hyperthermia for glioblastoma multiforme. Int J Radiat Oncol Biol Phys 1998;40:287–95. https://doi.org/10.1016/s0360-3016(97)00731-1.Search in Google Scholar PubMed
© 2025 the author(s), published by De Gruyter on behalf of Tech Science Press (TSP)
This work is licensed under the Creative Commons Attribution 4.0 International License.
Articles in the same Issue
- Frontmatter
- Review Articles
- Unveiling the hidden role of tumor-educated platelets in cancer: a promising marker for early diagnosis and treatment
- Multiple roles of mitochondria in tumorigenesis and treatment: from mechanistic insights to emerging therapeutic strategies
- The impact of JMJD5 on tumorigenesis: a literature review
- Research Articles
- A case-matched comparison of ER-α and ER-β expression between malignant and benign cystic pancreatic lesions
- Salivary gamma-glutamyltransferase activity as an indicator of redox homeostasis in breast cancer
- Cancer can be suppressed by alkalizing the tumor microenvironment: the effectiveness of “alkalization therapy” in cancer treatment
- Percutaneous-assisted laparoscopic bilateral salpingo-oophorectomy in BRCA-mutated patients: a retrospective comparative study
- ACAT2 contributes to cervical cancer tumorigenesis by regulating the expression of the downstream gene LATS1
- Rapid Communication
- Efficacy of mild hyperthermia in cancer therapy: balancing temperature and duration
- Case Report
- Orbital marginal zone B-cell lymphoma of mucosa-associated lymphoid tissue with amyloidosis: a case series and review of the literature
- Commentary
- Palliative external beam radiotherapy for dysphagia management in advanced esophageal cancer: a narrative perspective
- Endometriosis and endometriosis-associated ovarian cancer, possible connection and early diagnosis by evaluation of plasma microRNAs
Articles in the same Issue
- Frontmatter
- Review Articles
- Unveiling the hidden role of tumor-educated platelets in cancer: a promising marker for early diagnosis and treatment
- Multiple roles of mitochondria in tumorigenesis and treatment: from mechanistic insights to emerging therapeutic strategies
- The impact of JMJD5 on tumorigenesis: a literature review
- Research Articles
- A case-matched comparison of ER-α and ER-β expression between malignant and benign cystic pancreatic lesions
- Salivary gamma-glutamyltransferase activity as an indicator of redox homeostasis in breast cancer
- Cancer can be suppressed by alkalizing the tumor microenvironment: the effectiveness of “alkalization therapy” in cancer treatment
- Percutaneous-assisted laparoscopic bilateral salpingo-oophorectomy in BRCA-mutated patients: a retrospective comparative study
- ACAT2 contributes to cervical cancer tumorigenesis by regulating the expression of the downstream gene LATS1
- Rapid Communication
- Efficacy of mild hyperthermia in cancer therapy: balancing temperature and duration
- Case Report
- Orbital marginal zone B-cell lymphoma of mucosa-associated lymphoid tissue with amyloidosis: a case series and review of the literature
- Commentary
- Palliative external beam radiotherapy for dysphagia management in advanced esophageal cancer: a narrative perspective
- Endometriosis and endometriosis-associated ovarian cancer, possible connection and early diagnosis by evaluation of plasma microRNAs


